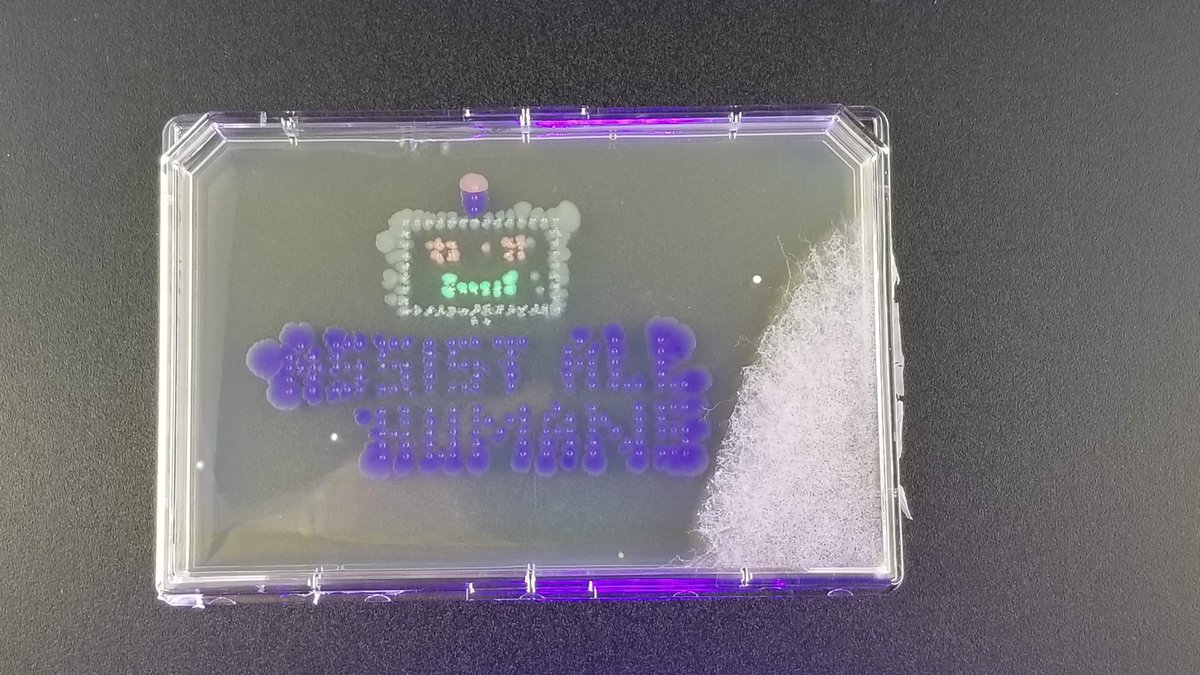
Check out this agar art by <a href="/CountrCultrLabs/">Counter Culture Labs</a>! They put bacteria into agar using our pipetting robot, and it expresses whatever color was added to it as it grows. Very cool 🎨 👩‍🔬👨‍🔬 #AgarArt #scienceisart #robots

iGEM Raiders
@ttuigem
Official Twitter of Texas Tech iGEM Team
ID: 728688791293038593
https://www.instagram.com/ttu_igemraiders/ 06-05-2016 20:52:01
172 Tweet
153 Followers
180 Following









TTU students, make sure you swing by the CISER Research Carnival on Wednesday from 10 AM to Noon in the SUB! Lots of orgs, programs, and tables. And, free snacks! SSO CISER @ TTU BiologicalSciencesTTU



Check out this agar art by Counter Culture Labs! They put bacteria into agar using our pipetting robot, and it expresses whatever color was added to it as it grows. Very cool 🎨 👩🔬👨🔬 #AgarArt #scienceisart #robots

We want to thank Bio Basic Inc. for sponsoring our iGEM team this year. We are extremely grateful for all the support! Without our sponsors our research would not be possible! #tturesearch #igemraider #biobasic


It’s today! Join a 2019 TED Fellow’s talk about #proteindesign and #proteinengineering, Room 302, 1:30pm chris bahl iGEM Headquarters iGEM Montpellier iGEM Technion iGEM Costa Rica iGEM BrownStanfordPrinctn William & Mary iGEM iGEM Wageningen iGEM Strasbourg iGEM USP São Carlos Valencia UPV iGEM Virginia iGEM iGEM Hamburg 2023 @IGEM_Amazonas

Thanks iGEM Raiders for stopping by our booth! You all look great in our t-shirt! Hope you enjoy the rest of #iGEM2019 #GiantJamboree





$6k neuroscience scholarship available until the end of the month for #blackandSTEM. Thank you Doris Tsao for supporting #BlackLivesMatter with concrete actions. Example for us all.






